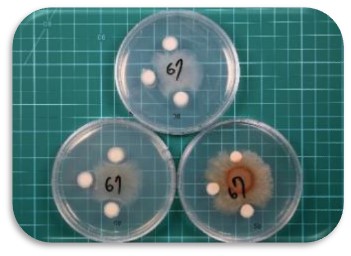

技術服務
其他服務▸微生物肥料服務
微生物肥料功能驗證
生物肥料主要以益生性微生物為主,其功能包括:固氮作用、增進溶解無效性營養、增進營養吸收、促進根系生長、增進植物抗逆境、保護根系、促進及保護植物生產功能等,國內學研界對此類產品研發已有多年經歷與成效,相關成果亦有技轉產業投入商業發展,所發展產品特性亦與歐美等國之溫帶菌系不同,可在熱帶及亞熱帶環境發揮優異效益。現行生物肥料登記品項及查驗規範僅有固氮、菌根菌及溶解無效性營養三品項,產業界有增加功效驗證品項需求。本所協助有意跨足生物製劑廠商進行商品化技術評估與建立適當解決方案。
微生物肥料功能驗證
目前生物肥料登記品項,以作物共生關係菌群及肥料提供養分功能為依據,但以間接促進作物生理表現之功能驗證方法則尚待建置。有關登記查驗品項之國際趨勢及國內需求有必要加以審視,並確認國際相關法規管理適切性,以協助國內產業之國際競爭力,建立國內最大產業利基之產品管理策略。

----------------------------------
聯絡人:黃文的 研究員
電話:(03)518-5156
傳真:(03)518-5143
電子郵件:1031104@mail.atri.org.tw